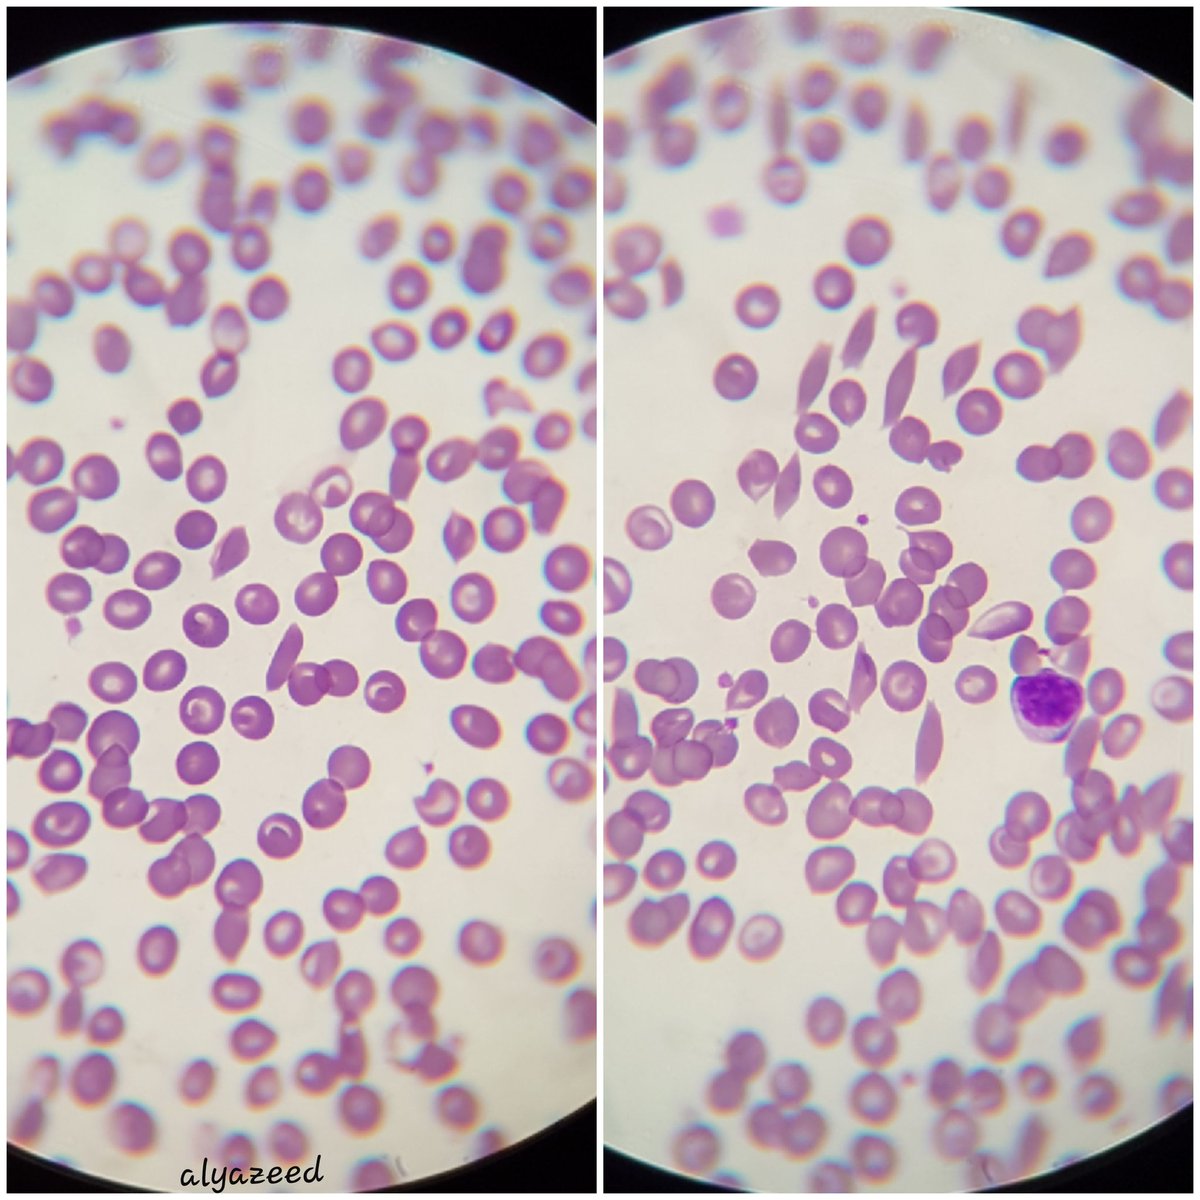

مرة جاني واحد وقال يبغى يفحص السكر التراكمي وانو مستعجل ويبغى يلحق على دوامه المهم، دخلت العينة حقته في الجهاز طلعت النتيجة صفر فقلت قبل ما اعيدها خليني اطلب منه عينة بول عشان نشوف السكر مبدئيا، ولما جاب لي العينة كان لونها
Dark yellow
والسكر Nil، سويت فحص ال bile طلع إيجابي!
Dark yellow
والسكر Nil، سويت فحص ال bile طلع إيجابي!
فقمت عملت blood film and CBC لكن تقريبا كلو كان تمام ماعدا ال RBCs ناقصة شوية وشفت لي كم خليه كذا كانها
Reversible sickle
مع وجود target cells
سألتو هل عندك أي انيما وراثية؟
قال انا شخصوني على اني حامل لل
Sickle anemia
فتذكرت احدى الطرق الل تحفز تكون خلايا الsickle
Reversible sickle
مع وجود target cells
سألتو هل عندك أي انيما وراثية؟
قال انا شخصوني على اني حامل لل
Sickle anemia
فتذكرت احدى الطرق الل تحفز تكون خلايا الsickle
طبعا طلع السكر %8.7
وكمان اتعمل له فحص ال
Hb-electrophoresis
وكانت النتيجه
نسبة
HbS 75%
مع ارتفاع
HbF
فطلع انو عندو نوعين انيميا
البحر المتوسط والمنجلية، فسبحان الله وجود ال HbF منع حدوث ال sickle crisis
عشان كذا اتشخص بالخطأ إنه حامل للأنيميا المنجلية
وكمان اتعمل له فحص ال
Hb-electrophoresis
وكانت النتيجه
نسبة
HbS 75%
مع ارتفاع
HbF
فطلع انو عندو نوعين انيميا
البحر المتوسط والمنجلية، فسبحان الله وجود ال HbF منع حدوث ال sickle crisis
عشان كذا اتشخص بالخطأ إنه حامل للأنيميا المنجلية
جاري تحميل الاقتراحات...